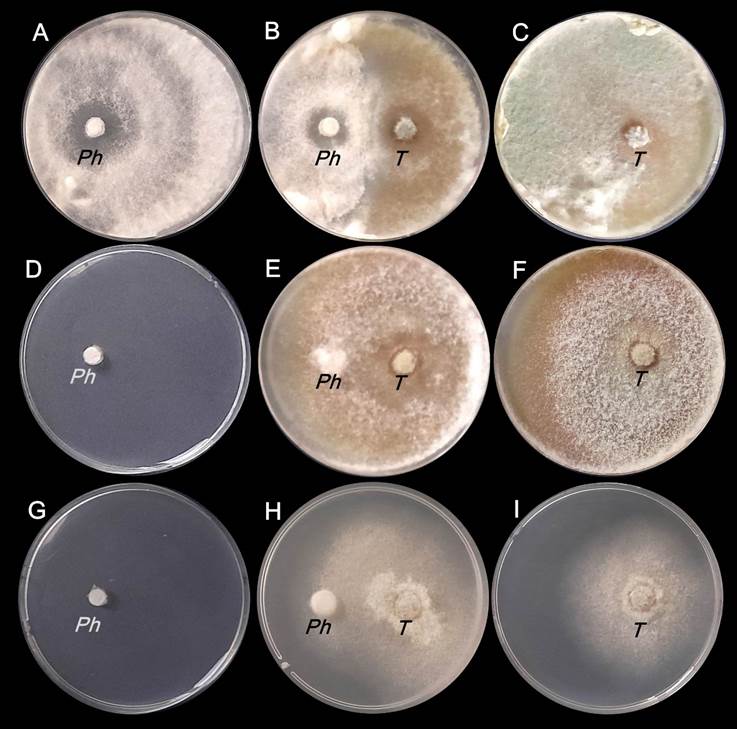
Colonias de Phomopsis spp y T harzianum al finalizar la etapa biofumigante d�a 7 de la incubaci�n A B C en ausencia de B juncea D E F con 10 g de B juncea G H I con 30 g de B juncea Ph Phomopsis spp T T harzianum
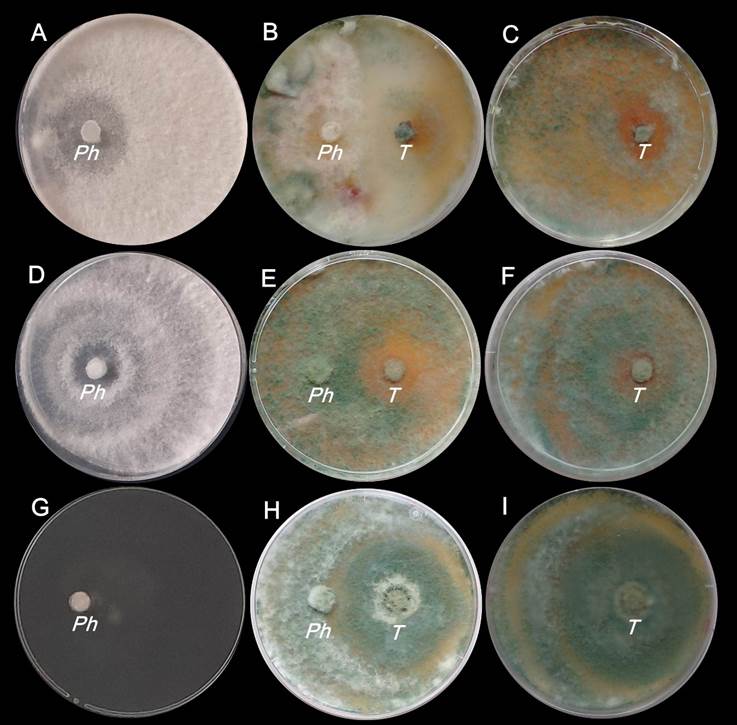
Colonias de Phomopsis spp. y T. harzianum al finalizar la etapa postbiofumigante (d�a 11 de la incubaci�n). A, B, C: en ausencia de B. juncea; D, E, F: con 10 g de B. juncea; G, H, I: con 30 g de B. juncea; Ph: Phomopsis spp.; T: T. harzianum.

Artículo Original
Sinergia entre la biofumigación con mostaza india y el hongo antagonista Trichoderma harzianum para el control de Phomopsis spp., bajo condiciones in vitro
Synergy between biofumigation with Indian mustard and the antagonist fungus Trichoderma harzianum for the control of Phomopsis spp., under in vitro conditions
Sinergia entre la biofumigación con mostaza india y el hongo antagonista Trichoderma harzianum para el control de Phomopsis spp., bajo condiciones in vitro
Siembra, vol. 11, núm. 2, e6619, 2024
Universidad Central del Ecuador

Esta obra está bajo una Licencia Creative Commons Atribución-NoComercial 4.0 Internacional.
Recepción: 07 Marzo 2024
Revisado: 15 Abril 2024
Aprobación: 30 Abril 2024
Resumen: El objetivo de este trabajo fue evaluar el efecto combinado de dos tácticas de biocontrol de plagas: la biofumigación con Brassicajuncea y la inoculación de Trichoderma harzianum, sobre el crecimiento in vitro del patógeno Phomopsis spp., agente etiológico de la cancrosis en el cultivo de pecán (Carya illinoinensis). Se trituraron plantas de B. juncea y se colocaron en envases de poliestireno en dosis de 10 y 30 g. Luego, en cada uno de estos recipientes se introdujo una caja de Petri con un disco con micelio dePhomopsis spp. o T. harzianum o ambos hongos (cultivo dual). Se incubó en cámara de cultivo. Los parámetros evaluados fueron la superficie de las colonias y el porcentaje de inhibición miceliar de Phomopsis spp. Los datos se analizaron con estadística no paramétrica mediante la prueba de Kruskal-Wallis. Se obtuvieron los siguientes resultados: i) B. juncea no afectó el crecimiento de T. harzianum; ii) la dosis de 30 g de B. juncea suprimió completamente el crecimiento de Phomopsis spp.; iii) T. harzianum inhibió significativamente el crecimiento de las colonias de Phomopsis spp.; iv) la combinación de T. harzianum y la biofumigación con 10 g de B. juncea mostró sinergia sobre el control del crecimiento de Phomopsis spp. La biofumigación con B. juncea, la aplicación de T. harzianum y la combinación de ambas técnicas podrían ser alternativas promisorias para el control biológico de Phomopsis spp.
Palabras clave: control biológico, antagonismo, Brassica juncea, Caryaillinoinensis.
Abstract: This work aimed to evaluate the combined effect of two pest biocontrol strategies: biofumigation with Brassica juncea and inoculation of Trichoderma harzianum, on the in vitro growth of the pathogen Phomopsis spp., an etiological agent of canker disease in pecan crops (Carya illinoinensis). B. juncea plants were crushed and placed in polystyrene recipients in doses of 10 and 30 g. Then, a Petri dish was introduced to each recipient, with a disk with a grown mycelium of Phomopsis spp. or T. harzianum, or both fungi (dual culture). Treatments were incubated in a culture chamber. The parameters evaluated were colonies’ surface area and percentage of mycelial inhibition of Phomopsis spp. Data were analyzed with non-parametric statistics using the Kruskal-Wallis test. The results indicated that: i) B. juncea did not affect the growth of T. harzianum; ii) the 30 g dose of B. juncea completely suppressed the growth of Phomopsis spp.; iii) T. harzianum significantly inhibited the growth of Phomopsis spp. colonies; iv) the combination of T. harzianum and biofumigation with 10 g of B. juncea showed synergy on the growth control of Phomopsis spp. Biofumigation with B. juncea, the application of T. harzianum, and the combination of both techniques could be promising alternatives for the biological control of Phomopsis spp.
Keywords: biocontrol, antagonism, Brassica juncea, Carya illinoinensis.
1. Introducción
La cancrosis ocasionada por Phomopsis spp. es una enfermedad que afecta al cultivo de pecán (Caryaillinoinensis [Wangenh.] K. Koch): provoca lesiones hundidas y alargadas que se localizan en las ramas, a nivel del cuello y en la zona de inserción del injerto con el pie y puede llegar a ocasionar el marchitamiento de las plantas (Noelting et al, 2016b; Perniola et al., 2023). En abril de 2014 se registró por primera vez la presencia de esta enfermedad en plantaciones de pecán de la provincia de Buenos Aires, Argentina (Noelting et al., 2016a).
En busca de alternativas agroecológicas para el control de Phomopsis spp., que sean amigables con el medio ambiente, se iniciaron estudios preliminares in vitro para evaluar la biofumigación con mostaza india (Brassicajuncea L. Czerniak) y la utilización del hongo biocontrolador Trichoderma harzianum Rifai, como herramientas para prevenir la enfermedad, en miras de su utilización para la desinfección de sustratos de siembra en la etapa de vivero, con el objetivo de evitar la infección en los estadios iniciales del crecimiento del pecán.
Una de las tácticas de control biológico utilizadas en el presente trabajo fue la biofumigación, que se basa en la liberación en el suelo de sustancias originadas por la descomposición de materiales orgánicos “biofumigantes” (Gimsing y Kirkegaard, 2006): residuos agroindustriales y de cosechas, estiércoles de diferentes animales, plantas frescas de especies brassicáceas y poáceas, etc. Al incorporar el biofumigante al suelo, se desencadena una serie de reacciones químicas que producen sustancias con actividad biocida: compuestos azufrados, ácido acético, amonio, etc. Asimismo, si el biofumigante es material fresco de especies brassicáceas (o algún subproducto industrial del mismo origen), su descomposición generará diferentes tipos de isotiocianatos, con variable grado de toxicidad sobre los organismos del suelo (Gowers, 2008; Harding y Wicks, 2001; Santos et al., 2021; Sarwar et al., 1998; Vandicke et al., 2020). Esto es debido a la degradación de unos compuestos denominados glucosinolatos (que están presentes en algunas células de las plantas brassicáceas), catalizada por la enzima mirosinasa, que se localiza en células cercanas a las anteriores y que entra en contacto con los glucosinolatos al producirse rupturas celulares (Chhajed et al., 2020; Kissen et al., 2009).
La mostaza india (B. juncea) es una de las especies brassicáceas más estudiadas para su utilización en biofumigación, con demostrado efecto fungistático sobre diversos hongos fitopatógenos: Rhizoctonia solani Kühn (Abdallah et al., 2020; Baysal-Gurel et al., 2020), Pythium ultimum Trow, Fusarium sambucinum Fuckel, Sclerotinia sclerotiorum (Lib.) de Bary (Larkin y Griffin, 2007), Fusarium oxysporum Schlechtend.: Fr. f. sp. lycopersici (Sacc.) W.C. Snyder & H.N. Hansen (Mayton et al., 1996), Verticillium dahliae Kleb. (Debiase et al., 2008; Michel y Lazzeri, 2008), Phytophthora capsici Leonian (Mason et al., 2023), Sclerotium rolfsii Sacc. (Chorzempa et al., 2019; Garain et al., 2021), Fusarium graminearum Schwabe (Perniola et al., 2012; 2021), Phytophthora nicotianae Breda de Haan (Baysal-Gurel et al., 2020), etc.
Otra técnica de control biológico empleada en este trabajo fue el antagonismo por Trichoderma spp. La utilización de este hongo como biocontrolador de plagas es una táctica agroecológica muy estudiada, debido a la facilidad de su cultivo y al amplio rango de control de fitopatógenos (Kullnig-Gradinger et al., 2002; Whipps, 2001), como resultado de múltiples mecanismos de acción, como el micoparasitismo, la competencia por los nutrientes y el espacio, la producción de antibióticos y la inducción de resistencia en las plantas (Guzmán-Guzmán et al., 2023; Poveda, 2021; Tyśkiewicz et al., 2022). Entre las especies más efectivas como biocontroladoras se encuentra T. harzianum, con demostrada acción sobre numerosos hongos: R. solani (Almeida et al., 2007), Fusarium solani (Mart.) Sacc. (Erazo et al., 2021), Fusarium sudanense SA Ahmed, Al-Hatmi & de Hoog (Larran et al., 2020), Phytophtora nicotianae Breda de Haan (Stefanova et al., 2004), Colletotrichum dematium (Pers. ex Fr.) Grove (Shovan et al., 2008), Fusarium. oxysporum f. sp. asparagi S.I. Cohen & Heald (Arriola et al., 2000), F. oxysporum f. sp. lycopersici (Zehra et al., 2017), Alternaria cerealis MT80847 (Mahmoud et al., 2021), Alternaria burnsii Uppal, Patel & Kamat, Fusarium oxysporum f. sp. cumini (Foc) (Deepak et al., 2008), Fusarium ipomoeae, Fusarium oxysporumSchlechtend: Fr., F. solani, Penicillium citrinumThom, Penicillium rotoruae O'Callahan & Vaidya, Aspergillus wentii Wehmer, Mucor variicolumellatus L. Wagner & G. Walther, Macrophominaphaseolina (Tassi) Goid. (Paul et al., 2021), Colletotrichum truncatum (Schweinitz) Andrus & WD Moore (Yadav et al., 2021), entre otros patógenos.
Con respecto a la utilización conjunta de la biofumigación y Trichoderma spp., Kirkegaard y Matthiessen (2004) determinaron que se requieren concentraciones bajas de isotiocianatos para lograr acción fungistática sobre patógenos, como Pythium spp. o Sclerotinia spp., pero para detener el crecimiento de Trichoderma spp. son necesarias dosis treinta veces superiores. En trabajos previos se ha demostrado que la biofumigación con B. juncea suprime el crecimiento in vitro de Phomopsis spp. (Perniola et al., 2023), pero no afecta al antagonista Trichoderma spp. (Perniola et. al., 2021). Asimismo, se observó sinergia de ambos métodos para el control in vitro de F. graminearum (Perniola et al., 2014).
Para determinar la factibilidad del uso combinado y simultáneo de la biofumigación con B. juncea y la aplicación de T. harzianum, como parte del manejo agroecológico integrado de la cancrosis del pecán, resulta importante profundizar los estudios sobre los efectos de la biofumigación sobre el hongo benéfico y los resultados de la interacción de las dos técnicas sobre Phomopsis spp., agente causal de dicha enfermedad.
El objetivo de este trabajo fue evaluar el efecto combinado de dos tácticas de biocontrol de plagas: la biofumigación con B. juncea y la inoculación de T. harzianum, sobre el crecimiento in vitro del patógeno Phomopsis spp.
2. Materiales y Métodos
2.1. Materiales
El material biofumigante se obtuvo de la parte aérea de mostaza india B. juncea cv. “SCOP-7”, variedad experimental desarrollada entre el Instituto Fitotécnico de Santa Catalina, Universidad Nacional de La Plata [IFSC] y la Facultad de Ciencias Agrarias, Universidad Nacional de Lomas de Zamora. El cultivo de B. juncea se sembró en el campo experimental del IFSC, Llavallol, Argentina, en mayo de 2023; cuando alcanzó el estadio de fin de fructificación (en octubre del mismo año), se cosechó la parte aérea completa, constituida por el tallo principal y sus ramificaciones, hojas y silicuas.
La cepa de Phomopsis spp. utilizada fue aislada de cancros hallados en ramas infectadas de pecán e identificada y multiplicada in vitro en los laboratorios del IFSC. El hongo T. harzianum fue aislado del suelo del campo experimental del IFSC.
2.2. Procedimientos
2.2.1 Estudio del efecto biofumigante de la mostaza india sobre Phomopsis spp. y T. harzianum
La evaluación del efecto biofumigante de la mostaza india sobre Phomopsis spp. y T. harzianum se basó en una metodología ampliamente utilizada para evaluar la acción de sustancias volátiles generadas por fungicidas de origen sintético o natural (Mayton et al., 1996; Perniola et al., 2014; 2023; Richardson y Munnecke, 1964). Se segó la parte aérea de las plantas de B. juncea, se cortó en trozos de 2 cm de largo y se trituró en una procesadora durante un minuto, aproximadamente. El material triturado se ubicó en recipientes de poliestireno (capacidad: 900 ml), en dos dosis de 10 y 30 g (M10 y M30, respectivamente). Previamente, las cepas de T. harzianum y Phomopsis spp. se multiplicaron durante catorce y siete días, respectivamente, en medio agar papa glucosado [APG] al 2 %, a 25 ± 2 ºC y oscuridad. Con un sacabocado se extrajeron discos de los respectivos cultivos de hongos, de 5 mm de diámetro, y se trasladaron de a uno a cajas de Petri con APG al 2 %. Las cajas de Petri con un disco de Phomopsis spp. o de T. harzianum se pusieron de a una dentro de los recipientes, apoyadas sobre soportes de plástico, quedando elevadas de 2 a 3 cm por encima del biofumigante. Los recipientes se cerraron con tapas plásticas. Para el control se utilizó la misma metodología, pero no se agregó el biofumigante.
2.2.2. Determinación del antagonismo de T. harzianum sobre Phomopsis spp.
Para determinar el potencial biocontrolador de T. harzianum sobre Phomopsis spp. se empleó la técnica de cultivo dual (Morton y Stroube, 1955). Se colocaron en cajas de Petri con APG al 2 %, un disco de 5 mm de diámetro de Phomopsis spp. y otro de T. harzianum, distanciados 4 cm uno del otro. Las cajas de Petri se ubicaron dentro de recipientes de 900 ml y estos se cerraron con tapas plásticas. Se utilizó el mismo control que fue citado en la sección 2.2.1.
2.2.3. Combinación de T. harzianum y la biofumigación con mostaza india para el control de Phomopsis spp.
Para estudiar el efecto conjunto de T. harzianum y la biofumigación con mostaza india sobre el crecimiento de Phomopsis spp., se combinó el cultivo dual con la técnica de biofumigación, anteriormente descriptos.
2.2.4. Incubación
La incubación se efectuó en cámara de crecimiento a 25 ± 2 ºC y oscuridad. La primera etapa del ensayo (etapa biofumigante) se extendió por siete días, durante los cuales las unidades experimentales que contenían B. juncea estuvieron expuestas a la acción directa de los gases biofumigantes. Al séptimo día se retiró el material biofumigante de los envases de poliestireno y se continuó con la incubación hasta el día once (etapa postbiofumigante), bajo las mismas condiciones de temperatura y oscuridad citadas anteriormente, con el objeto de estudiar el crecimiento de los hongos después de haber estado expuestos a los gases.
2.3. Evaluaciones
Las mediciones se realizaron a los siete y once días, al finalizar las etapas biofumigante y postbiofumigante, respectivamente. Se midieron los diámetros de las colonias de ambos microorganismos y se calcularon sus superficies. A fin de evaluar el efecto de los diferentes tratamientos de biocontrol (biofumigación, T. harzianum y la combinación de ambos) sobre el hongo patógeno, se calculó el porcentaje de inhibición miceliar de Phomopsis spp. [.] mediante la ecuación [1] (Rekha et al., 2012, Vincent, 1947), donde . es el diámetro de la colonia de Phomopsis spp. en el control y, . es el diámetro de la colonia de Phomopsis spp. en el tratamiento de biocontrol.
 [1]
[1]Los tratamientos se consideraron “supresores del hongo” cuando la superficie media de la colonia fue inferior al 50 % de la media del control (Mayton et al., 1996; Perniola et al., 2012).
2.4. Diseño experimental y análisis estadístico
En todos los procedimientos realizados, se empleó un diseño completamente aleatorizado con cinco repeticiones por tratamiento. Debido a que los datos no cumplieron los supuestos de normalidad y homocedasticidad, se aplicó estadística no paramétrica mediante la prueba de Kruskal-Wallis y la separación de medias se realizó con la prueba de comparaciones múltiples de muestras independientes por parejas. Se utilizó el programa Statistica 7.
3. Resultados y Discusión
3.1. Efecto de la biofumigación con B. juncea sobre Phomopsis spp.
En M10, al finalizar la etapa biofumigante, las colonias de Phomopsis spp. presentaron muy escaso crecimiento, aunque no hubo diferencia significativa con respecto al control. En cambio, en M30 no se registró crecimiento de Phomopsis spp. y difirió significativamente del tratamiento M10 y el control (p value = 0,0023; H = 12,13) (Tabla 1 y Figura 1A, 1D, 1G). Con respecto a la etapa postbiofumigante, se observó reanudación del crecimiento de Phomopsis spp. en M10, pero no en M30 (Tabla 1 y Figura 2A, 2D, 2G).
| Tratamiento | Superficie promedio de la colonia (cm2)† | |
| Etapa biofumigante* | Etapa post-biofumigante** | |
| Control B. juncea - 10 g B. juncea - 30 g | 63,62 a 8,11 (87,25 %) ab 0,00 (100,00 %) b | 63,62 a 56,64 (10,97 %) a 0,00 (100,00 %) b |
Table 1. Effect of biofumigation with B. juncea on the growth of Phomopsis spp colonies.
† Los valores entre paréntesis muestran el porcentaje de inhibición miceliar de Phomopsis spp. En cada columna, los valores con letras distintas indican diferencias significativas por la prueba de Kruskal-Wallis (* p value = 0,0023; H = 12,13 y ** p value = 0,0018; H = 12,67). / Values in parentheses show the percentage of mycelial inhibition of Phomopsis spp. In each column, values with different letters indicate significant differences by Kruskal-Wallis test (* p value = 0.0023; H = 12.13 and ** p value = 0.0018; H = 12.67).
Figura 1
Colonias de Phomopsis spp y T harzianum al finalizar la etapa biofumigante día 7 de la incubación A B C en ausencia de B juncea D E F con 10 g de B juncea G H I con 30 g de B juncea Ph Phomopsis spp T T harzianum
Figure 1. Colonies of Phomopsis spp. and T. harzianum at the end of the biofumigant stage (day 7 of incubation). A, B, C: in the absence of B. juncea; D, E, F: with 10 g of B. juncea; G, H, I: with 30 g of B. juncea; Ph: Phomopsis spp.; T: T. harzianum.
Figura 2
Colonias de Phomopsis spp. y T. harzianum al finalizar la etapa postbiofumigante (día 11 de la incubación). A, B, C: en ausencia de B. juncea; D, E, F: con 10 g de B. juncea; G, H, I: con 30 g de B. juncea; Ph: Phomopsis spp.; T: T. harzianum.
Figure 2. Colonies of Phomopsis spp. and T. harzianum at the end of the post-biofumigant stage (day 11 of incubation). A, B, C: in the absence of B. juncea; D, E, F: with 10 g of B. juncea; G, H, I: with 30 g of B. juncea; Ph: Phomopsis spp.; T: T. harzianum.
La biofumigación con 30 g de B. juncea suprimió totalmente el crecimiento de Phomopsis spp., provocando la muerte del hongo.
En un trabajo previo donde se evaluó la biofumigación con B. juncea sobre Phomopsis spp. (Perniola et al., 2023), se observó supresión in vitro del crecimiento del hongo con dosis de 30 y 60 g de B. juncea; sin embargo, la reducción del crecimiento fue menor cuando se utilizó material biofumigante proveniente de un cultivo de B. juncea sembrado en fecha subóptima, que presentaba menor contenido de glucosinolatos. Esto denota que la biofumigación con mostaza india generaría resultados variables en la reducción del crecimiento de Phomopsis spp., dependiendo del momento de siembra de B. juncea y su contenido de glucosinolatos.
Actualmente, no hay otros registros sobre el efecto de la biofumigación con B. juncea sobre Phomopsis spp.
3.2. Efecto de la biofumigación con B. juncea sobre T. harzianum
Al finalizar la etapa biofumigante en el tratamiento M10, el hongo T. harzianum colonizó casi completamente las cajas de Petri y no se registró diferencia significativa con respecto al control sin biofumigante. En cambio, en el tratamiento M30 se observó reducción significativa de la superficie de las colonias de T. harzianum con respecto al control y M10 (p value = 0; H = 25) (Tabla 2 y Figura 1C, 1F, 1I); no obstante, una vez retirado el biofumigante, el hongo reactivó su crecimiento y colonizó la totalidad de la caja de Petri. En la etapa postbiofumigante no se registraron diferencias significativas entre tratamientos (p value = 1; H = 0) (Tabla 2 y Figura 2C, 2F, 2I).
| Tratamiento | Superficie promedio de la colonia (cm2)† | |
| Etapa biofumigante* | Etapa post-biofumigante** | |
| Control B. juncea - 10 g B. juncea - 30 g | 63,62 a 62,18 a 32,46 b | 63,62 a 63,62 a 63,62 a |
Table 2. Effect of biofumigation with B. juncea on the growth of T. harzianum of colonies.
† En cada columna, los valores con letras distintas indican diferencias significativas por la prueba de Kruskal-Wallis (* p value = 0; H = 25 y ** p value = 1; H = 0). / In each column, values with different letters indicate significant differences by Kruskal-Wallis test (* p value = 0; H = 25 y ** p value = 1; H = 0).Los resultados muestran que la biofumigación con 10 g de B. juncea no suprimió el crecimiento de las colonias de T. harzianum, en cambio, la dosis de 30 g generó una inhibición temporal del crecimiento del hongo, sin provocar su muerte: T. harzianum reanudó su crecimiento una vez que finalizó la biofumigación.
Estos resultados coinciden con los hallados en trabajos previos. Perniola et al. (2014; 2016) observaron, en ensayos metodológicamente similares al presente, que la biofumigación con 5 a 55 g de B. juncea (en el estadio de fin de fructificación) no afectó el crecimiento in vitro de Trichoderma spp.; Chorzempa et al. (2019) hallaron que la biofumigación en condiciones de campo con 2,26 kg m-2 de plantas frescas trituradas de B. juncea en el estadio de fin de fructificación, no suprimió al hongo antagonista T. harzianum. Asimismo, Garain et al. (2021) observaron que aislados nativos de Trichoderma spp. T-Nam fueron altamente tolerantes a tratamientos de biofumigación con hojas frescas maceradas de B. juncea, var. Pusa Mahak (valor de concentración inhibidora del 99 %: 9,46 g por 127 ml de espacio aéreo, equivalente a 67,04 g por 900 ml); Prasad et al. (2018) determinaron que T. harzianum fue menos sensible a los gases volátiles de varias especies del género Brassica (incluida B. juncea) en comparación con varios patógenos ensayados (R. solani, S. rolfsii, Fusarium oxysporum f. sp. ciceris (Padwick) Matuo & K. Sato y S. sclerotiorum).
3.3. Interacción de T. harzianum y Phomopsis spp. en el cultivo dual sin biofumigación
En el cultivo dual sin biofumigación se registraron los mismos valores de superficies de colonias a los 7 y 11 días de incubación, para ambos hongos. Las colonias de Phomopsis spp. resultaron de diámetro significativamente menor que las observadas en el cultivo individual (p value = 0,0053; H = 7,76); por el contrario, las colonias de .. harzianum presentaron el mismo diámetro que en el cultivo individual (p value = 1; H = 0) (Tabla 3, Figura 1A, 1B, 1C y Figura 2A, 2B, 2C).
| Tratamiento | Superficie promedio de la colonia (cm2)† | |
| Phomopsis spp.* | T. harzianum** | |
| Cultivo individual Cultivo dual | 63,62 a 32,80 (48,44 %) b | 63,62 a 63,62 a |
Table 3. Antagonistic effects of T. harzianum on Phomopsis spp.
† Los valores entre paréntesis muestran el porcentaje de inhibición miceliar de Phomopsis spp. En cada columna, los valores con letras distintas indican diferencias significativas por la prueba de Kruskal-Wallis (* p value = 0,0053; H = 7,76 y ** p value = 1; H = 0). / Values in parentheses show the percentage of mycelial inhibition of Phomopsis spp. In each column, values with different letters indicate significant differences by Kruskal-Wallis test (* p value = 0.0053; H = 7.76 y ** p value = 1; H = 0).T. harzianum inhibió significativamente el crecimiento de Phomopsis spp., aunque no hubo efecto supresor, ya que las colonias del patógeno en el cultivo dual superaron el 50 % de la superficie media del control, siendo el porcentaje de inhibición miceliar de Phomopsis spp. de 48,44 % (Tabla 3). El micelio de T. harzianum se extendió sobre el de Phomopsis spp. y cubrió toda la superficie de la caja de Petri: fue poco notorio a simple vista al día 7 de la incubación (Figura 1B), pero se evidenció marcadamente al día 11, debido a la producción de conidios de color verde (Figura 2B).
Otros autores encontraron mayores porcentajes de inhibición del crecimiento de Phomopsis spp. en cultivos duales con T. harzianum, variables según la especie del patógeno y la cepa del antagonista. Crovo y Clemente (2015) hallaron un 50 % de inhibición del crecimiento de Phomopsis spp. a los 3,5 días de incubación, aunque este porcentaje se incrementó a más del 60 % al día 7. Jakatimath et al. (2017) observaron porcentajes de inhibición miceliar de Phomopsis vexans (Sacc. & Syd.) variables entre 56,33 y 70,66 %, según la cepa de T. harzianum con la que se confrontó al patógeno. López-López et al. (2023) observaron 82,2 % de inhibición de Phomopsis perseae Zerova cuando se lo confrontó con T. harzianum cepa TSONM6.
3.4. Acción conjunta de T. harzianum y la biofumigación con mostaza india sobre Phomopsis spp.
Los tratamientos que combinaban biofumigación y T. harzianum mostraron un porcentaje de inhibición miceliar de Phomopsis spp. significativamente mayor que el tratamiento con T. harzianum sin biofumigante. No se observaron diferencias significativas entre las distintas dosis de B. juncea, tanto en la etapa biofumigante como en la postbiofumigante (p value = 0,0013; H = 13,29) (Tabla 4, Figura 1B, 1E, 1H y Figura 2B, 2E y 2H).
| Tratamiento | Porcentaje de inhibición miceliar de Phomopsis spp.† | |
| Etapa biofumigante | Etapa post-biofumigante | |
| T. harzianum | 48,44 % a | 48,44 % a |
| T. harzianum + B. juncea - 10 g | 100,00 % b | 100,00 % b |
| T. harzianum + B. juncea - 30 g | 100,00 % b | 100,00 % b |
Table 4. Joint effects of T. harzianum and Indian mustard biofumigation (Brassica juncea) on Phomopsis spp.
† Los valores con letras distintas indican diferencias significativas por la prueba de Kruskal-Wallis (p value = 0,0013; H = 13,29). / Values with different letters indicate significant differences by Kruskal-Wallis test (p value = 0.0013; H = 13.29).Al finalizar el ensayo, la combinación del antagonista T. harzianum y la biofumigación con 10 g de B. juncea tuvo un efecto sinérgico en el control del crecimiento de Phomopsis spp.: el porcentaje de inhibición miceliar en el tratamiento que combinaba las dos técnicas fue significativamente mayor que los observados en los tratamientos que aplicaban esas técnicas de biocontrol por separado (Tablas 4, 1 y 3).
En la literatura no encontramos investigaciones sobre la acción conjunta de T. harzianum y la biofumigación con B. juncea sobre Phomopsis spp. No obstante, existen registros de la aplicación simultánea de ambas tácticas de biocontrol en otros patógenos. En un ensayo previo donde se evaluó in vitro el efecto combinado de Trichoderma spp. y la biofumigación con plantas frescas de mostaza india (en el estadio de fin de fructificación) sobre F. graminearum, se observó un efecto sinérgico sobre el control del crecimiento del patógeno, con dosis de 5 y 10 g de biofumigante (Perniola et al., 2014). Otros investigadores también observaron efectos favorables al utilizar conjuntamente la biofumigación y Trichoderma spp. Garain et al. (2021) hallaron reducción de la incidencia de la pudrición inducida por S. rolfsii en Piper betle L. en un 95,66 %, debido al efecto combinado de la biofumigación con B. juncea y la enmienda de Trichoderma spp. en el suelo.
4. Conclusiones
Los resultados de este ensayo concuerdan con los obtenidos en pruebas in vitro y a campo realizadas previamente y permiten confirmar que la técnica de biocontrol con el hongo antagonista T. harzianum puede ser considerada compatible con la biofumigación con B. juncea. El crecimiento de T. harzianum y su potencial efecto de biocontrol sobre Phomopsis spp., no serían afectados por la biofumigación con B. juncea.
La utilización combinada de T. harzianum y la biofumigación con 10 g de B. juncea, tendría un efecto sinérgico sobre el control del crecimiento de Phomopsis spp.
Asimismo, la dosis de 30 g de B. juncea es suficiente para lograr la supresión total del patógeno, en las condiciones del presente ensayo.
La biofumigación con B. juncea, la aplicación de T. harzianum y la combinación de ambas técnicas podrían ser alternativas promisorias para el control biológico de Phomopsis spp.
Financiamiento
-
Subsidio Lomas CyT 2022, Universidad Nacional de Lomas de Zamora.
-
Fondos generaros por servicios a terceros, Instituto Fitotécnico de Santa Catalina, Facultad de Ciencias Agrarias y Forestales, Universidad Nacional de La Plata.
Contribuciones de los autores
-
Omar Salvador Perniola: conceptualización, análisis formal, investigación, metodología, administración del proyecto, validación, visualización, redacción – borrador original, redacción – revisión y edición.
-
María Cristina Isabel Noelting: conceptualización, investigación, metodología, administración del proyecto, validación, visualización, redacción – revisión y edición.
-
Silvia Elena Chorzempa: conceptualización, análisis formal, adquisición de fondos, investigación, metodología, administración del proyecto, recursos, redacción – revisión y edición.
-
Mónica Beatriz Aulicino: análisis formal, recursos, redacción – revisión y edición.
-
Guillermo Martín Mantz: investigación, redacción – revisión y edición.
-
Marta Mónica Astiz Gassó: conceptualización, investigación, metodología, supervisión, recursos, redacción – revisión y edición.
Implicaciones éticas
Los autores declaran que no existen implicaciones éticas.
Conflicto de interés
Los autores declaran que no existen conflictos de interés financieros o no financieros que podrían haber influido en el trabajo presentado en este artículo.
Referencias
Abdallah, I., Yehia, R., y Kandil, M. Ah. (2020). Biofumigation potential of Indian mustard (Brassica juncea) to manage Rhizoctonia solani. Egyptian Journal of Biological Pest Control, 30, 99. https://doi.org/10.1186/s41938-020-00297-y
Almeida, F. B. dos R., Cerqueira, F. M., Silva, R. do N., Ulhoa, C. J., y Lima, A. L. (2007). Mycoparasitism studies of Trichoderma harzianum strains against Rhizoctonia solani: evaluation of coiling and hydrolytic enzyme production. Biotechnology Letters, 29(8), 1189-1193. https://doi.org/10.1007/s10529-007-9372-z
Arriola, L. L., Hausbeck, M. K., Rogers, J., y Safir, G. R. (2000). The effect of Trichoderma harzianum and arbuscular mycorrhizae on fusarium root rot in asparagus. Hortechnology, 10(1), 141-144. https://doi.org/10.21273/HORTTECH.10.1.141
Baysal-Gurel, F., Liyanapathiranage, P., y Addesso, K. M. (2020). Effect of Brassica crop-based biofumigation on soilborne disease suppression in woody ornamentals. Canadian Journal of Plant Pathology, 42(1), 94-106. https://doi.org/10.1080/07060661.2019.1625444
Chhajed, S., Mostafa, I., He, Y., Abou-Hashem, M., El-Domiaty, M., y Chen, S. (2020). Glucosinolate biosynthesis and the glucosinolate–myrosinase system in plant defense. Agronomy, 10(11), 1786. https://doi.org/10.3390/agronomy10111786
Chorzempa, S. E., Perniola, O. S., Subelza, L. F., Barca, H. J., Sánchez, S. E., Rodas Alonso, R., Molina, M. C., y Astiz Gassó, M. M. (2019). Biofumigación con Brassica juncea. Efecto sobre Trichoderma harzianum, Sclerotiumrolfsii . Lactuca sativa. Boletín de la Sociedad Argentina de Botánica, 54(Supl. XXXVII Jornadas Argentinas de Botánica), 136-137. https://botanicaargentina.org.ar/wp-content/uploads/2019/09/Jornadas-Argentinas-de-Bot%C3%A1nica-2019-1-1.pdf
Crovo, V., y Clemente, G. E. (2015). Eficacia de fungicidas de síntesis y biológico en base a Trichoderma harzianum para controlar patógenos de semillas de soja. FAVE Sección Ciencias Agrarias, 14(2), 55-68. https://doi.org/10.14409/fa.v14i2.5720
Debiase, G., Rotolo, C., Miazzi, M., Pollastro, S., Verdini, L., De Mastro, G., y Faretra, F. (2008). Biofumigant activity of Brassicaceae against soil-borne fungi. En 3rd International Biofumigation Symposium (p. 59). CSIRO. Canberra. https://ausveg.com.au/app/data/technical-insights/docs/VG07191_complete.pdf
Deepak, P., Saran, L., y Lal, G. (2008). Control of wilt and blight diseases of cumin through antagonistic fungi under in vitro and field conditions. Notulae Botanicae Horti Agrobotanici Cluj-Napoca, 36(2), 91-96. https://doi.org/10.15835/nbha36276
Erazo, J. G., Palacios, S. A., Pastor, N., Giordano, F. D., Rovera, M., Reynoso, M. M., Venisse, J. S., y Torres, A. M. (2021). Biocontrol mechanisms of Trichoderma harzianumITEM 3636 against peanut brown root rot caused by Fusarium solani RC 386. Biological Control, 164, 1049-9644. https://doi.org/10.1016/j.biocontrol.2021.104774
Garain, P. K., Mondal, B. y Dutta, S. (2021). Effect of biofumigation by Indian mustard (Brassica juncea L.) on Sclerotium rolfsii Sacc., causing collar rot in betelvine (Piper betle L.). Indian Phytopathology, 74, 1015-1025. https://doi.org/10.1007/s42360-021-00407-2
Gimsing, A. L., y Kirkegaard, J. A. (2006). Glucosinolate and isothiocyanate concentration in soil following incorporation of Brassica biofumigants. Soil Biology and Biochemistry, 38(8), 2255-2264. https://doi.org/10.1016/j.soilbio.2006.01.024
Gowers, S. (2008). Selection of B. napus and B. rapa lines for biofumigation potential. En 3rd International Biofumigation Symposium (p. 79). CSIRO. Canberra. https://ausveg.com.au/app/data/technical-insights/docs/VG07191_complete.pdf
Guzmán-Guzmán, P., Kumar, A., de los Santos-Villalobos, S., Parra-Cota, F. I., Orozco-Mosqueda, M. del C., Fadiji, A. E., Hyder, S., Babalola, O. O., y Santoyo, G. (2023). Trichoderma species: Our best fungal allies in the biocontrol of plant diseases—A review. Plants, 12(3), 432. https://doi.org/10.3390/plants12030432
Harding, R. B., y Wicks, T. J. (2001). Effects of incorporating Brassica and cereal cover crop residues on soil populations of Verticillium dahliae. En Proceedings of Second Soilborne Diseases Conference (pp. 148-149). Lorne.
Jakatimath, S. P., Mesta, R. K., Mushrif, S. K., Biradar, I. B., y Ajjappalavar, P. S. (2017). In vitro evaluation of fungicides, botanicals and bio-agents against Phomopsis vexans, the causal agent of fruit rot of brinjal. Journal of Pure and Applied Microbiology, 11(1), 229-235. http://dx.doi.org/10.22207/JPAM.11.1.29
Kirkegaard, J. A., y Matthiessen, J. N. (2004). Developing and refining the biofumigation concept. Agroindustria, 3(3): 233-239.
Kissen, R., Rossiter, J. T., y Bones, A. M. (2009). The ‘mustard oil bomb’: not so easy to assemble?! Localization, expression and distribution of the components of the myrosinase enzyme system. Phytochemistry Reviews, 8, 69-86. https://doi.org/10.1007/s11101-008-9109-1
Kullnig-Gradinger, C. M., Szakacs, G., y Kubicek, C. P. (2002). Phylogeny and evolution of the genus Trichoderma: a multigene approach. Mycological Research, 106(7), 757-767. https://doi.org/10.1017/S0953756202006172
Larkin, R. P., y Griffin, T. S. (2007). Control of soilborne potato diseases using Brassica green manures. Crop Protection, 26(7), 1067-1077. https://doi.org/10.1016/j.cropro.2006.10.004
Larran, S., Santamarina Siurana, M. P., Roselló Caselles, J., Simón, M. R., y Perelló, A. (2020). In Vitro antagonistic activity of Trichoderma harzianumagainst Fusarium sudanense causing seedling blight and seed rot on wheat. ACS Omega, 5(36), 23276-23283. http://dx.doi.org/10.1021/acsomega.0c03090
López-López, M. E., Del-Toro-Sánchez, C. L., Ochoa-Ascencio, S., Aguilar-López, J. A., Martínez Cruz, O., Madrigal-Pulido, J. A., Robles-García, M. A., Bernal-Mercado, A. T., Ávila-Novoa, M. G., Guerrero-Medina, P. J., y Gutiérrez-Lomeli, M. (2023). Antagonismo de cepas de Trichoderma spp. aisladas en Tanaxuri, Michoacán, México contra patógenos postcosecha del fruto de aguacate (Persea americana Mill). Biotecnia, 25(1), 24-33. https://doi.org/10.18633/biotecnia.v25i1.1726
Mahmoud, G. A.-E., Abdel-Sater, M. A., Al-Amery, E., y Hussein, N. A. (2021). Controlling Alternaria cerealis MT808477 tomato phytopathogen by Trichoderma harzianum and tracking the plant physiological changes. Plants, 10(9), 1846. https://doi.org/10.3390/plants10091846
Mason, M., Lehnhoff, E. A., Trainor, P. J., y Sanogo, S. (2023). Suppression of Phytophthora capsici in chile pepper using Brassica juncea and Hordeum vulgare cover crop residues and Trichoderma harzianum as a biocontrol agent. Plant Disease, 107(11), 3457-3463. http://dx.doi.org/10.1094/PDIS-10-22-2485-RE
Mayton, H. S., Olivier, C., Vaughn, S. F., y Loria, R. (1996). Correlation of fungicidal activity of Brassica especies with allyl-isotiocyanate production in macerated leaf tissue. Phytopathology, 86(3), 267-271. http://dx.doi.org/10.1094/Phyto-86-267
Michel, V. V., y Lazzeri, L. (2008). Biofumigation to control Verticillium wilt influenced by plant species and soil types. En 3rd International Biofumigation Symposium (p. 62). CSIRO. Canberra. https://ausveg.com.au/app/data/technical-insights/docs/VG07191_complete.pdf
Morton, D. T. y Stroube, N. H. (1955). Antagonistic and stimulatory effects of microorganism upon Sclerotium rolfsii. Phytopathology, 45, 419-420. https://www.cabidigitallibrary.org/doi/full/10.5555/19561100103
Noelting, M. C. I., Mantz, G., Maiale, S. J., y Molina, M. C. (2016a). Occurrence of Phomopsis sp. causing cankers on pecan trees in Buenos Aires province, Argentina. New Disease Reports, 33, 9. http://dx.doi.org/10.5197/j.2044-0588.2016.033.009
Noelting, M. C. I., Mantz, G., y Molina, M. C. (2016b). Detección de una nueva patología emergente en el cultivo de pecán en la provincia de Bs. As. https://www.agro.unlp.edu.ar/sites/default/files/slides/pecan_2016.pdf
Paul, N. C., Park, S., Liu, H., Lee, J. G., Han, G. H., Kim, H., y Sang, H. (2021). Fungi associated with postharvest diseases of sweet potato storage roots and in vitro antagonistic assay of Trichoderma harzianum against the diseases. Journal of Fungi, 7(11), 927. https://doi.org/10.3390/jof7110927
Perniola, O. S., Chorzempa, S. E., D’Amico, M., Staltari, S., Molina, M. C., y Astiz Gassó, M. M. (2021). Obtención de la primera variedad argentina de mostaza india: Santa Catalina UNLP, para su utilización como biofumigante. Innovación y Desarrollo Tecnológico y Social, 3(1), 1-23. https://doi.org/10.24215/26838559e027
Perniola, O. S., Chorzempa, S. E., Staltari, S., Astiz Gassó, M. M., Galian, L. R., y Molina, M. C. (2016). Biofumigación con Brassica juncea L. Czerniak y Sinapis albaL. Acción sobre el crecimiento in vitro de Trichoderma spp. y Azospirillumbrasilense Tarrand, Krieg et Döbereiner. Revista de Protección Vegetal, 31(1), 57-62. http://scielo.sld.cu/scielo.php?script=sci_arttext&pid=S1010-27522016000100008
Perniola, O. S., Noelting, M. C. I., Chorzempa, S. E., Mantz, G. M., Alonso, D. O., y Astiz Gassó, M. M. (2023). Biofumigación con mostaza india: actividad supresora sobre Phomopsis spp., agente causal de cancrosis en pecán. En Primer Congreso Nacional de Innovación Social. La Plata.
Perniola, O. S., Staltari, S., Chorzempa, S. E., Astiz Gassó, M. M., y Molina, M. C. (2014). Control biológico de Fusarium graminearum: utilización de Trichoderma spp. y biofumigación con parte aérea de Brassica juncea. Revista de la Facultad de Ciencias Agrarias UNCuyo, 46(2), 45-56. https://revistas.uncu.edu.ar/ojs3/index.php/RFCA/article/view/5603
Perniola, O. S., Staltari, S., Chorzempa, S. E., y Molina, M. C. (2012). Biofumigación con Brassicáceas: actividad supresora sobre Fusarium graminearum. Revista de la Facultad de Agronomía UNLP, 111(1), 48-53. http://revista-vieja.agro.unlp.edu.ar/index.php/revagro/article/view/71
Poveda, J. (2021). Trichoderma as biocontrol agent against pests: New uses for a mycoparasite. Biological Control, 159, 104634. https://doi.org/10.1016/j.biocontrol.2021.104634
Prasad, P., Kumar, J., y Pandey, S. (2018). Investigating disease controlling ability of Brassica volatiles and their compatibility with Trichoderma harzianum. Proceedings of the National Academy of Sciences, India Section B: Biological Science, 88, 887-896. https://doi.org/10.1007/s40011-016-0829-5
Rekha, D., Patil, M. B., Shridhar Shetty, P., Swamy, K. M., y Rajini, B. G. (2012). In vitro screening of native Trichoderma isolates against Sclerotium rolfsii causing collar rot of ground nut. International Journal of Science and Nature, 3(1), 117-120. https://www.scienceandnature.org/IJSN_Vol3(1)2012.php
Richardson, L. T., y Munnecke, D. E. (1964). A bioassay for volatile toxicants from fungicides in soil. Phytopathology, 54, 836-839.
Santos, C. A. dos ., Abboud, A. C. de S., y Carmo, M. G. F. do. (2021). Biofumigation with species of the Brassicaceae family: a review. Ciência Rural, 51(1), e20200440. https://doi.org/10.1590/0103-8478cr2020040
Sarwar, M., Kirkegaard, J. A., Wong, P. T. W., y Desmarchelier, J. M. (1998). Biofumigation potential of brassicas III. In vitro toxicity of isothiocyanates to soil-borne fungal pathogens. Plant Soil, 201,103-112. https://doi.org/10.1023/A:1004381129991
Shovan, L. R., Bhuiyan, K. A., Begum, J. A., y Pervez, Z. (2008). In vitro control of Colletotrichum dematium causing anthracnose of soybean by fungicides, plant extracts and Trichoderma harzianum. International Journal of Sustainable Crop Production, 3(3), 10-17. https://ggfjournals.com/content/papers/v3i210-17
Stefanova, M., Sandoval, I., Martínez, M. L., Heredia, I., Ariosa, M. D., y Arévalo, R. (2004). Control de hongos fitopatógenos del suelo en semilleros de tabaco con Trichoderma harzianum. Fitosanidad, 8(2), 35-38. https://www.redalyc.org/articulo.oa?id=209117836008
Tyśkiewicz, R., Nowak, A., Ozimek, E., y Jaroszuk-Ściseł, J. (2022). Trichoderma: The current status of its application in agriculture for the biocontrol of fungal phytopathogens and stimulation of plant growth. International Journal of Molecular Sciences, 23(4), 2329. https://doi.org/10.3390/ijms23042329
Vandicke, J., De Visschere, K., Deconinck, S., Leenknecht, D., Vermeir, P., Audenaert, K., y Haesaert, G. (2020). Uncovering the biofumigant capacity of allyl isothiocyanate from several Brassicaceae crops against Fusarium pathogens in maize. Journal of the Science of Food and Agriculture, 100(15), 5476-5486. https://doi.org/10.1002/jsfa.10599
Vincent, J. M. (1947). The esters of 4-hydroxybenzoic acid and related compounds. Part I. Methods for the study of their fungistatic properties. Journal of the Society of Chemical Industry, 66(5), 149-155. https://doi.org/10.1002/jctb.5000660504
Whipps, J. M. (2001). Microbial interactions and biocontrol in the rhizosphere. Journal of Experimental Botany, 52(suppl_1), 487-511. https://doi.org/10.1093/jexbot/52.suppl_1.487
Yadav, M., Dubey, M. K., y Upadhyay, R. S. (2021). Systemic resistance in chilli pepper against anthracnose (caused by Colletotrichum truncatum) induced by Trichoderma harzianum, Trichoderma asperellum and Paenibacillusdendritiformis. Journal of Fungi, 7(4), 307. https://doi.org/10.3390/jof7040307
Zehra, A., Meena, M., Dubey, M. K., Aamir, M., y Upadhyay, R. S. (2017). Synergistic effects of plant defense elicitors and Trichoderma harzianum on enhanced induction of antioxidant defense system in tomato against fusarium wilt disease. Botanical Studies, 58, 44. https://doi.org/10.1186/s40529-017-0198-2
Notas de autor
omarperniola@yahoo.com.ar
Información adicional
e-location: e6619
